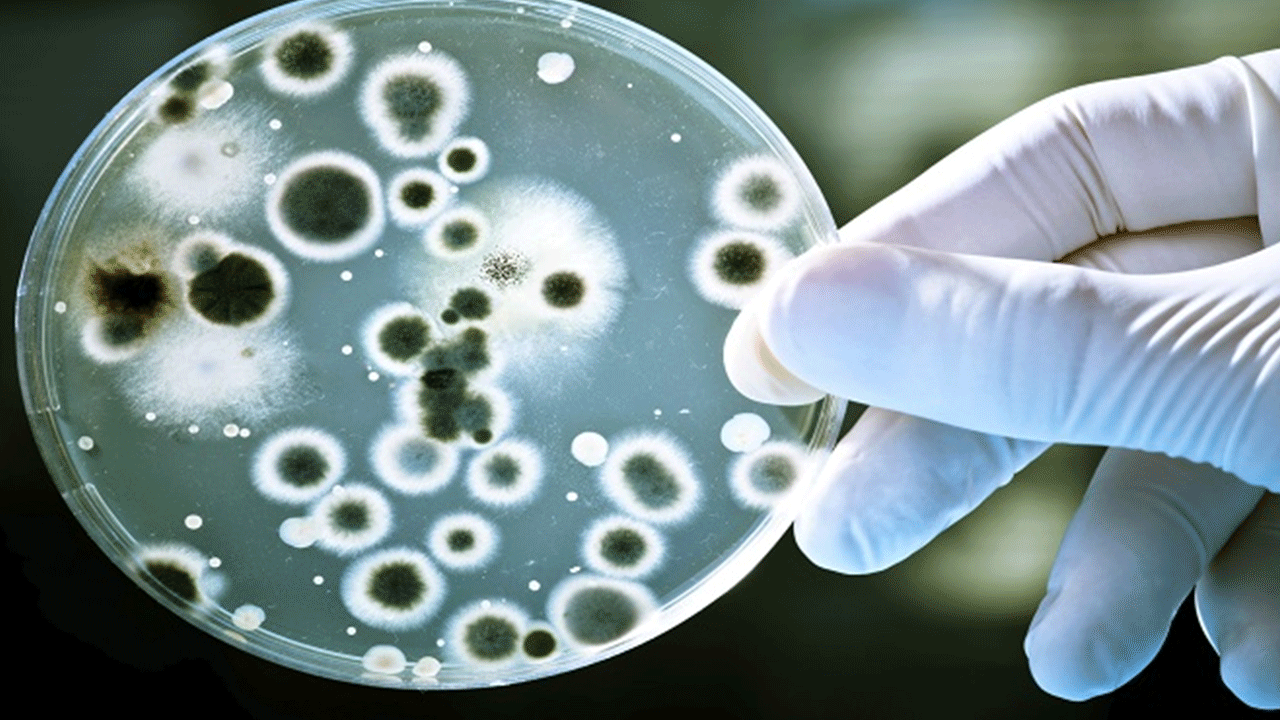
Foto - Bilim adamlarından küresel çağrı: Malezya'da tespit edildi!

Bilim adamlarından küresel çağrı: Malezya'da tespit edildi!
126 bakteri örneğini inceleyen Malezyalı araştırmacılar antibiyotik dirençli ve ölümcül olduğu duyurulan “süper bakteri” tespit etti. Bilim insanları, bakterinin halk sağlığı açısından ciddi bir tehdit oluşturduğunun altını çizdi.